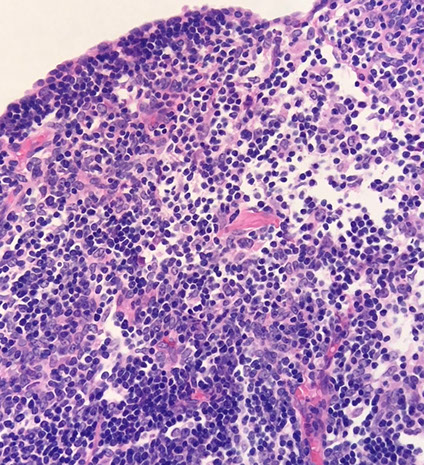
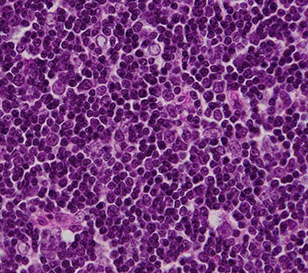

Thymus
Embryology, Anatomy, Histology
Multilocular thymic cyst
Thymic follicular hyperplasia
True thymic hyperplasia
Thymoma
Thymic carcinoma
Note: Primary lymphoid organs = BM and thymus
- site of lymphocyte birth and maturation by a process that does not involve antigens; have no follicles and make mature naive lymphocytes
Secondary lymphoid organ (LNs, spleen, MALT) activate naive lymphocytes with antigen and have follicles
Embryology
Derived from endodermic 3rd (pharyngeal) branchial pouches, next to inferior parathyroids (which are superior to the superior parathyroids [4th pouch] at the time)
- inf parathyroids and thymus migrate down past the 4th pouch
- capsule comes from neural crest mesenchyme and divides the thymus into (incomplete) lobules
- thyic epithelial cells form a 3D matrix c macrophages and then gets thymocyte precursors from BM via BVs
- produces T cells by 17 WGA (T cells from liver before then)
- thymic epithelial cells make CK5/18, but after Foxn1 transcription factor, cortical thymic cells make only CK18 (does colonal selection); medullary thymic cells first get Foxn1, then autoimmune regulator (aire) transcription factors (do colonal deletion of autoreactive T cells)
- 98% of T cells fail selection process
-- aire deletions cause autoimmune polyendocrinopathy-candidiasis-ectodermal dystrophy (APECED) syndrome
- production of T cells in adults is decreased bc thymus involutes after puberty
-- T cells in liver and intestines of adult may still be enough to launch a T cell response, but is not as much as it would be in a child
Anatomy
Primary lymphoid organ in inferior neck post to manubrium and ant to pericardium
- irrigated by ant intercostal and ant mediastinal branches of internal thoracic arteries
- lymph drains to tracheobrochial, parasternal and brachiocephalic LNs
Histology
Thymus is site of T-cell diff and maturation, cortex (darker) c immature and medulla (lighter) c mature T cells
- overall has two lobes that are subdivided into incomplete lobules, surrounded by capsule that involutes into trabeculae c BVs inside; macrophages seen in both cortex and medulla
- cortex has thymic (cortical) epithelial cells that are linked by desmosomes forming a double basal lamina bwt endothelial cells and capillaries, forming the blood-thymus barrier
- T cells mature from Double-neg, to dbl +, to single + in the cortex selection
- medulla has epithelial (medullary) reticular cells, Hassall's corpuscles (stimulate thymic dendritic cells c cytokine thymic stromal lymphprotein)

--- blood vessel
--- Hassal corpuscle
Trabecula
Cortex ----------
Medulla
Multilocular thymic cyst
asdf
Thymic follicular hyperplasia
Has been assoc c variety of autoimmune dz
- assoc c myasthenia gravis, and pts tend to do better once excised
Although can be associated with secondary disease, true thymic hyperplasia is defined as increase in age-adjusted weight and size of the tymus with retained lobular architecture
Micro: the normal lobular follicular architecture is preserved ad has normal thymic weight with increased lymphoid follicles with germinal centers in the interstitium and corticomedullary junction
- the epithelial component is inconspicuous
- there is no influx of reactive inflammatory cells
Thymoma
rare, generally indolent though considered malignant, arise from thymic epithelial cells, wide age distribution, M=F
- posterior margin usually a true margin as it is dissected from the anterior pericardium
- normal thymic architecture is effaced
- a wide proportion are associated with myasthenia gravis (6-70%) and/or paraneoplastic syndromes, depending on the subtype
- are generally slow-rowing and tend to be well-demarcated or well-encapsulated
Histologically subclassified as A, AB, or B1-B3, based on "organotypical" features (i.e. histologic resemblance to normal thymic development)
- Mixed patterns may occur within the same tumor, necessitating the need for adequate sampling
-- Recommended to classify thymomas with heterogenous patterns by the predominant pattern, followed by the minor components in 10% increments
Type A and AB is more spindly cells
-- most type AB have focal immature lymphocytes (thymocytes, type-B like) and focal lymph poor areas (type A-like)
- B1-B3 more epithelioid
-- B1 has more lymphs and less epithelioid cells, B3 has less lymph and more epithelioid cells
- B2 intermediate, with some epithelial cell clusters
-- medullary islands essentially req'd to dx type B1
Variant called micronodular thymoma, c spindly cells in compact swirled nodules, usually mature (CD20+) B-cells
IHC: thymocytes (immature lymphs) + for CD99, CD1a and TdT; epithelial cells CK / p63+
- negative CD5 and CD117 (vs thymic carcinoma)
DDx: T-LBL, thymic hyperplasia, thymic carcinoma
Thymoma
Thymoma AB

thymoma type B1
B3 thymoma


Multinodular thymoma with lymphoid stroma (MNTL)
Rare subtype that accounts for ~1% of all thymomas
- are rarely associated with myasthenia gravis
- vast majority are stage I tumors, and the remaining are minimally invasive (stage II) tumors
Gross: often soft and friable
Micro: characterized by multiple, discrete solid nests or cords of tumor cells surrounded by abundant lymphoid stroma with lymphoid follicles
- germinal centers may be seen
- nests often have bland spindle to ovoid epithelial cells with scant cytoplasm with finely dispersed chromatin and inconspicuous nucleoli
IHC: epithelial cell nests can be highlighted using panK, CK 5/6, CK 19, p63, and PAX8
- unlide type A thymoma, the spindled epithelial cells of MNTL lack aberrant expression of CD20
- MNTL has a higher degree of lymphocytic infiltration than type A thymoma
- the lymphoid stroma of MNTL lacks epithelial cells and is comprised of a mixture of CD20+ B-cells, and mature CD3+/TdT- T-cells
MNTL


Typical Carcinoid Tumor
Pretty rare, low-grade neuroendocrine neoplasm evoid of necrosis with <2 mits / 2mm^2
- 1/4 are assoc c MEN1
Micro: show neuroendocrine features such as rosetting, nesting, and trabecular growth patten invested by a delicate vascular network
IHC: +NE markers
Thymic carcinoma
~ 1/4 of all thymic neoplasms, of which squamous cell carcinoma is the most common type
- ONLY thymic disease not assoc c myasthenia gravis
Micro: polygonal with a greater degree of nuclear atypia with infiltration and jagged islands in a desmoplastic stroma
- overt malignant behavior, clearly malignant by cytology, appear similar to carcinoma in other organs
IHC: (+) keratins. Polyclonal PAX8 is positive in about 75% of cases.
-- Thymic carcinomas often exhibit positive staining with CD5 and CD117, while thymomas are typically negative
Poorly differentiated thyroid carcinoma (PDTC) is a malignant neoplasm of thyroid follicular cells with high-grade features, but without anaplastic histology.
- PDTC diagnosis is based on Turin consensus criteria and is characterized by the presence of a solid/trabecular/insular growth pattern, absence of conventional papillary thyroid carcinoma nuclear features, and presence of at least one of the following: convoluted nuclei, mitotic count greater than or equal to 3 per 2 mm2, and tumor necrosis.
IHC: (+) keratins, thyroglobulin, TTF1, and monoclonal PAX8,
- negative calcitonin, CD5, CD117, and neuroendocrine markers.
-- Thyroglobulin expression is focal in poorly differentiated areas, often with a dot-like paranuclear pattern.
References
1.
